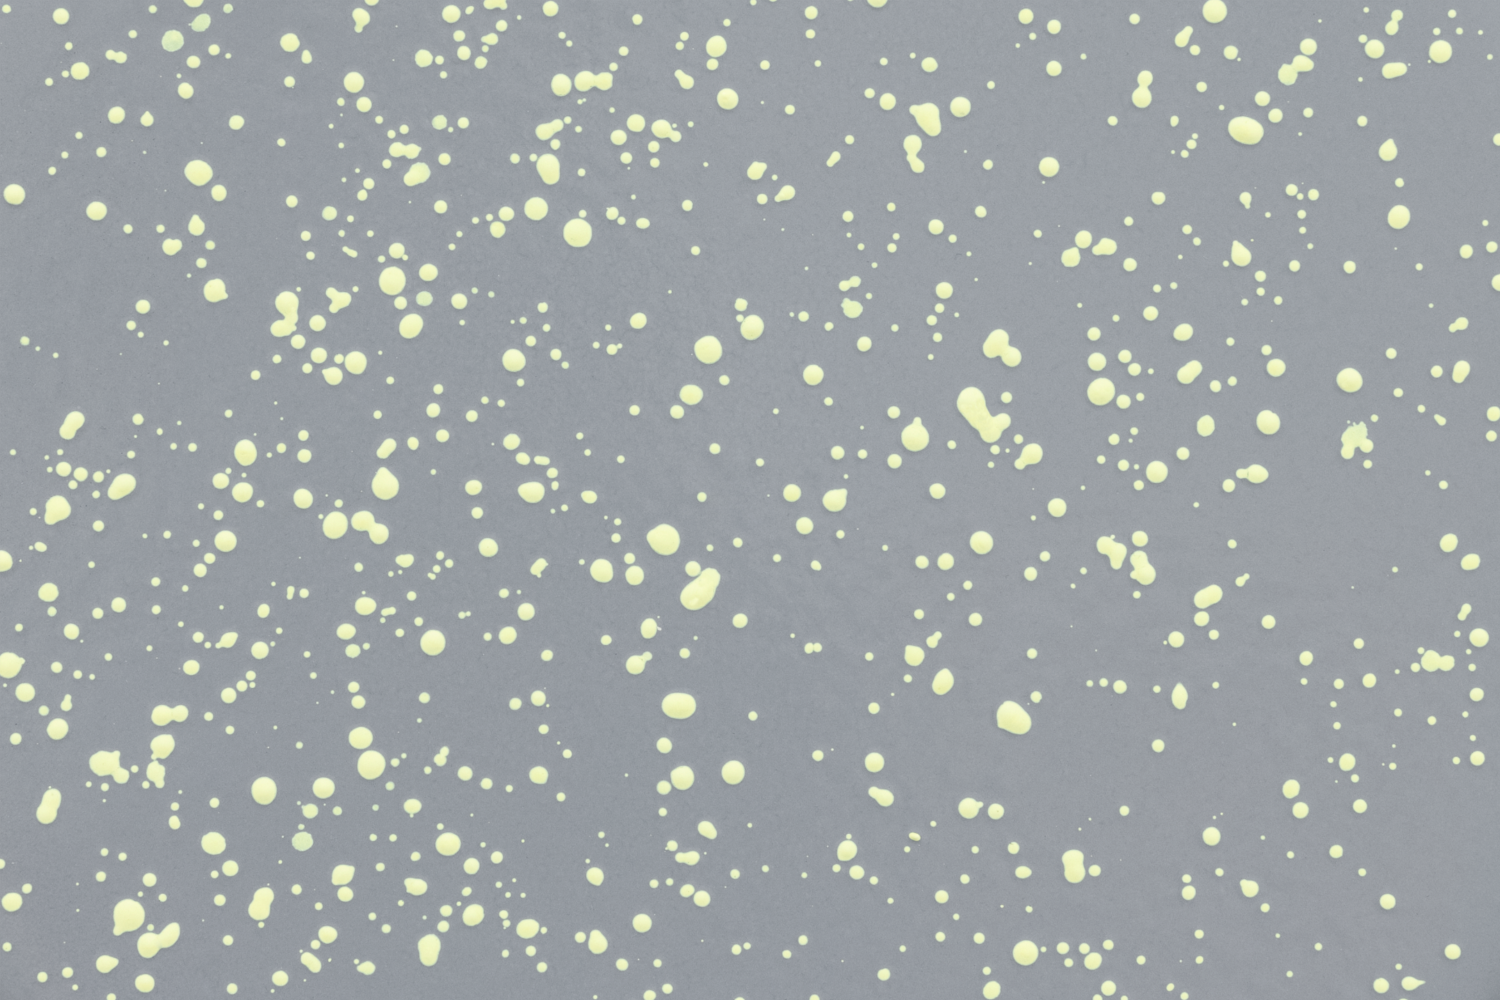

Returns Policy
If you wish to return an item for reasons other than damage or defect, you may do so within 30 days of receipt of delivery for all items that are not listed as FINAL SALE or MADE TO ORDER. Eligible items must be returned in their original condition and packaging.
Unauthorized returns will be refused, and a 20% restocking fee applies to all approved, non-defective returns. Customers are responsible for all return shipping costs. We can pre-generate a return label or customer may return using their preferred shipper. We highly recommend insuring return shipments and getting tracking. Credit will not be issued for items damaged in transit due to inadequate packaging. Refunds will be issued to the original payment method within 1-5 business days of inspection and warehouse acceptance.
FINAL SALE and MADE TO ORDER items are not eligible for returns able to be returned. All FINAL SALE and MADE TO ORDER items are clearly labeled as such on the product page. If your FINAL SALE or MADE TO ORDER item is damage or has a defect, please contact us within 72 hours of delivery.
To initiate a return, please contact us at concierge@studioperdiem.com to obtain a return authorization number.
International orders (shipped outside the United States) are considered FINAL SALE and not eligible for return.
Cancellations
We aim to keep you informed about your order status, though package preparation, shipping and supply chain changes may affect timelines. Orders (excluding MADE TO ORDER, Upholstery and Custom Orders) may be canceled for a full refund if they have not yet left our warehouse.
Defective or Incorrect Items
If your item arrives with a manufacturing defect or was shipped in error, we will replace it at no cost to you. Please provide our claims team photos of the error in advance to obtain a replacement authorization.
If your order or product arrives damaged, please follow the procedures below.
1. Ensure you sign for the shipment. Either by you or a representative must confirm receipt of all listed packages in undamaged condition. If a shipment is refused, you are responsible for all shipping and return costs and may forfeit your deposit. Delivery delays, regardless of cause, do not constitute grounds for order cancellation or refusal once the item has shipped. Orders may be delivered in multiple shipments.
2. If the packaging shows visible damage (e.g., crushed boxes, broken crates, moisture), note this in writing on the delivery receipt before signing and take a photograph as reference. Studio Per Diem cannot complete a damage claim unless all damage is properly documented at the time of delivery.
To ensure prompt and effective resolution, please ensure your receiver follows these steps:
-
Even if damage is suspected, accept the shipment to avoid delays.
-
Please open and inspect carefully. Note any visible damage on the delivery receipt at the time of signing. Claims will be denied if damage is not documented. “Subject to inspection” is not a valid notation.
-
Provide clear photos of both the damage and packaging.
-
Send claim details and photos to concierge@studioperdiem.com within 5 business days. We cannot accept damage claims received after this period will not be accepted.
-
Please Keep All Packaging – Retain all original packaging, boxes and enclosure packing materials until your claim is resolved. If packaging is discarded, we are not responsible for repackaging fees that may ensue.
 Furniture
Furniture Lighting
Lighting Ceiling Lights
Ceiling Lights Wall Lights
Wall Lights Table Lamps
Table Lamps Floor Lamps
Floor Lamps Outdoor Lighting
Outdoor Lighting Glassware
Glassware Tableware
Tableware Serveware
Serveware Kids Tableware
Kids Tableware Kitchen & Table Linens
Kitchen & Table Linens Kitchen Tools & Storage
Kitchen Tools & Storage Kitchen & Dining
Kitchen & Dining Pillows
Pillows Throw Blankets
Throw Blankets Candles
Candles Candle Holders & Votives
Candle Holders & Votives Holiday Tablescape
Holiday Tablescape Holiday
Holiday